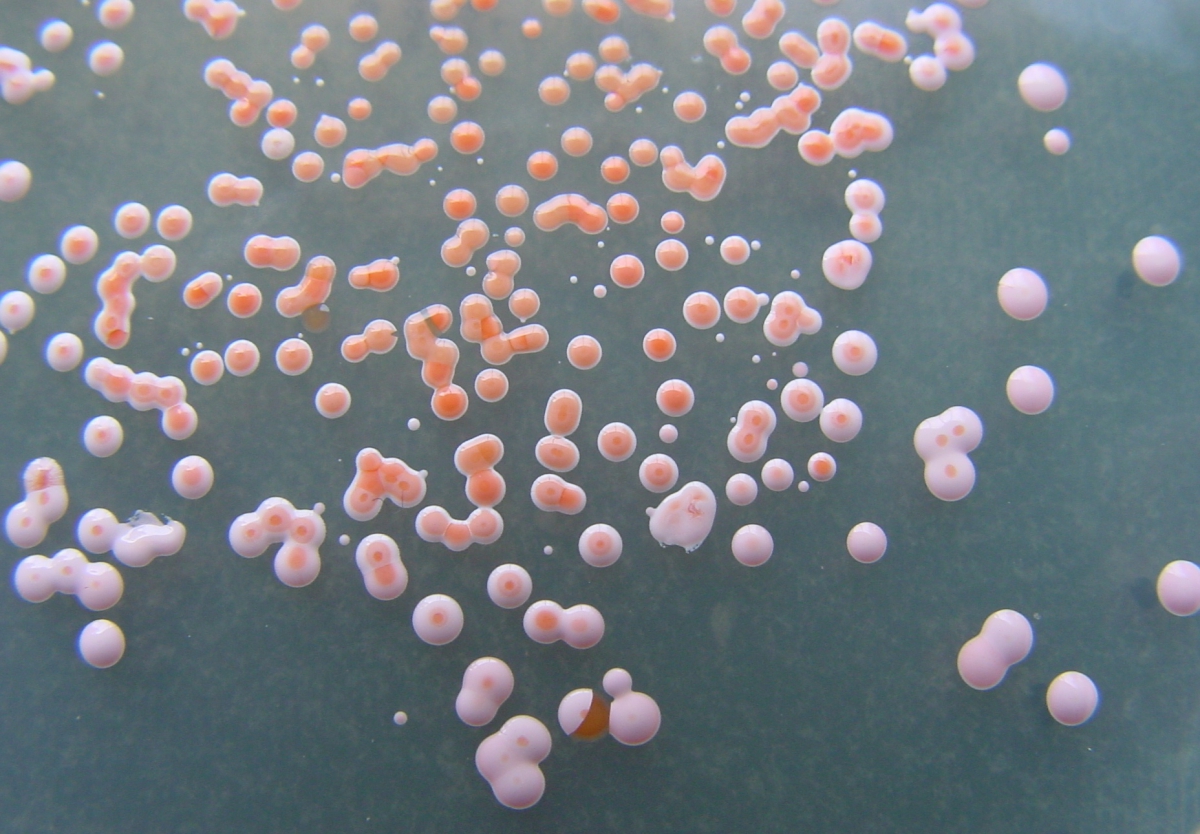

Животные в их естественной среде: фототрофы и дикая природа

Раздел: Ключ к успеху